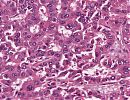

71-jährige Patientin mit bekannter fokaler nodulärer Hyperplasie
Anamnese
Seit 2003 bekannte Raumforderung im linken Leberlappen, welche im CT und MRT die diagnostischen Kriterien einer fokalen nodulären Hyperplasie erfüllt. In den ambulant durchgeführten Verlaufskontrollen fiel zuletzt ein AFP-Anstieg auf 3323 IU/ml auf, so dass der hochgradige Verdacht auf HCC gestellt wurde und die Patientin sich in der chirurgischen Klinik vorstellte.
Diagnostik
Labor:
| Tumormarker | Werte | Normbereich |
|---|---|---|
| AFP | 3323 IU/ml | bis 20 IU/ml |
| CA 19-9 | 35,4 U/ml | bis 38,0 U/ml |
| CEA | 1,5 µg/l | bis 2,5 g/l |
PE der Leber: Die durchgeführte Feinnadelbiopsie der Leber ergab ein hepatozelluläres Karzinom.
Umfelddiagnostik: Die weitere Umfelddiagnostik mittels Ösophago-Gastro-Duodenoskopie (ÖGP), Coloskopie und Sonographie des Abdomens zeigte keinen Hinweis auf weitere Tumormanifestationen.
Procedere
Die Patientin wurde zur geplanten Hemihepatektomie links mit Entfernung der Gallenblase aufgenommen. Intraoperativ zeigte sich kein Hinweis auf eine Peritonealkarzinose.
Makroskopie
18 × 10,5 × 8 cm messendes linksseitiges Hemihepatektomiepräparat. Auf der Schnittfläche ein gelb-grünlicher, angedeutet polyzyklisch begrenzter und max. 6,5 cm großer tumoröser Herdbefund mit Vorwölbung der intakten Kapsel. Peritumoral stellt sich makroskopisch eine Invasion großer Venenäste dar. Makroskopisch kein zirrhotischer Parenchymumbau.
Diagnose
Mittelgradig differenziertes hepatozelluläres Karzinom (G2)
Mikroskopie
Histologisch sieht man einen invasiven epithelialen Tumor, aufgebaut aus polygonalen, hepatozytenähnlichen Tumorzellen mit mässig pleomorphen, ovalären Kernen und teils distinkten Nukleolen. Der Tumor wächst teils pseudoglandulär teils solide-mikrotrabekulär, infiltriert per continuitatem in große Lebervenenäste sowie in Perineuralscheiden. Im nicht neoplastische Leberparenchym eine ca. 30%ige und überwiegend grobtropfige Parenchymverfettug neben einer portalen und fokal akzentuierten perisinusiodalen Fibrose. Die Resektionsränder sind tumorfrei.
Virtuelle Mikroskopie
TNM-Klassifikation: pT3, pNX
Grading: G2
R-Klassifikation: R0
Klinischer Verlauf
Im postoperativen Verlauf trat bei der Patientin Übelkeit und Erbrechen auf; in der ÖGD zeigte sich eine antrumbetonte, erosive Pangastritis, mit negativem HUT-Test. (kein Nachweis einer Helicobacter pylori Infektion). Ca. zwei Wochen postoperativ wurde die Patientin in einem gutem Allgemeinzustand und afebril entlassen.
Klinische Korrelation
Eine adjuvante medikamentöse Therapie (Sorafenib) ist bei diesem Tumorstadium nicht indiziert, jedoch sollten alle 3 Monate Nachsorgekontrollen (AFP, Abdomen-Sonografie) im ersten Jahr post OP durchgeführt werden.
Ungewöhnlich ist das Auftretern des Leberzellkarzinoms in einer nicht-zirrhotischen Leber. Die große Mehrheit (70-90%) der Leberzellkarzinome treten in einer Leberzirrhose auf).
Die Ätiologie des Leberzellkarzinoms ist gut definiert und beinhaltet neben einer chronischen Virushepatitis (HBV, HCV, HDV) vor allem einen chronischen Alkoholabusus und ein metabolisches Syndrom im Rahmen eines Diabetes mellitus Typ II. Ferner gelten eine hereditäre Hämochromatose, ein alpha1-Antitrypsin-Mangel und die Nahrungmittelkontamination mit Aflatoxin B1 als ätiologisch relevant.
Leberzellkarzinome, die infolge eines metabolischen Syndroms auftreten, zeigen meist, wie in diesem Fall, keinen assoziierten zirrhotischen Parenchymumbau. Die zugrundeliegenden pathogenetischen Zusammenhänge sind bislang ungeklärt. Bei dieser Patientin bestand eine diabetische Stoffwechsellage.
Die Pangastritis entwickelte sich vermutlich stressbedingt nach Operation und intensiv-medizinischer Therapie.
Kasuistiken Mikro

Bilder
Abb. 158:

Abb. 159:
Leber - Lehrtexte
- Biliäres Hamartom
- Hepatozelluläres Karzinom
- Intrahepatisches Cholangiokarzinom
- Lebermetastasen
- Leberzirrhose
Leber - weitere Kasuistiken
Related articlesLeber - Literatur
Organpathologie-Atlas